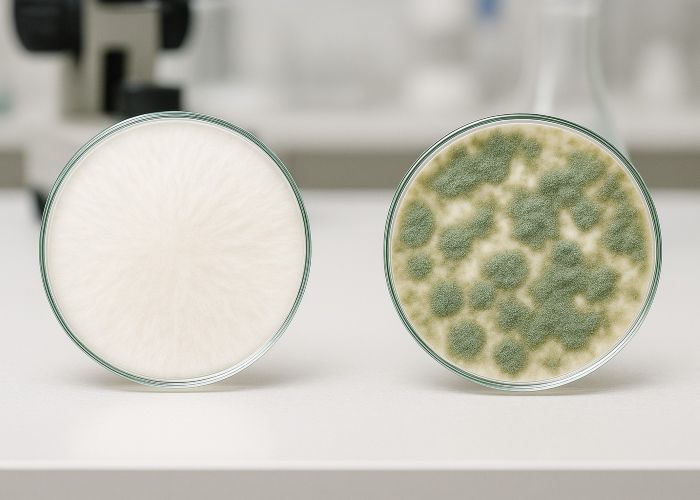

Заражение триходермой — один из наиболее частых и неприятных сценариев потери урожая при культивации псилоцибиновых грибов. Этот агрессивный микопаразит может погубить мицелий буквально за пару дней, причем даже при соблюдении всех базовых рекомендаций. Независимо от уровня подготовки, с триходермой сталкиваются все, кто работает с грибами в домашних или лабораторных условиях: от новичков до опытных микологов. Ее споры повсеместны, а устойчивость к внешним факторам делает риск заражения постоянным.
В интернете много поверхностных советов, которые часто повторяются без уточнений — «белый налет», «быстро растет», «похожа на мицелий». На практике этого недостаточно для принятия грамотных решений. Эта статья — не обзор признаков, а подробная инструкция: как точно распознать триходерму, какие действия необходимы сразу после обнаружения, почему лечение не работает, и какие шаги реально снижают риск повторного заражения. Только проверенные методы, основанные на микологической практике и понимании биологии возбудителя.
Сценарий: как это обычно происходит
Чаще всего заражение становится заметным на стадии инкубации или в самом начале плодоношения. Сначала появляется белый, пушистый налет на поверхности субстрата — визуально он почти неотличим от нормального мицелия Psilocybe, особенно если у грибовода нет большого опыта. Затем наблюдается чуть более быстрый рост по сравнению с основным мицелием и незначительное увлажнение поверхности в месте поражения. Это может сопровождаться тонким, еле заметным изменением текстуры — рыхлость, ватность.
Примерно через 24–36 часов налет начинает приобретать зеленоватый оттенок — сначала бледный, затем все более насыщенный, вплоть до оливкового или ярко-изумрудного. Этот момент означает одно: триходерма вошла в фазу активной споруляции, и заражение вышло за рамки локальной зоны.
И тут чаще всего начинаются стандартные ошибки:
- попытка просто соскоблить пораженный участок и «зачистить» его до здорового слоя;
- использование народных средств вроде соли, гипса или соды, якобы блокирующих развитие;
- точечная дезинфекция — капли перекиси водорода, спирта или хлоргексидина;
- изоляция участка плесени фольгой или пленкой, в надежде «запереть» ее;
- или, наоборот, полное бездействие под лозунгом «а вдруг мицелий справится».
На практике ни один из этих методов не останавливает заражение. Триходерма уже проникла вглубь субстрата, активно разрушает грибной мицелий и готовится к колонизации следующего блока. Каждая отсрочка увеличивает риск вторичного заражения.
Почему частичное удаление не работает
Триходерма — это не просто плесень на поверхности. Ее гифы развиваются в глубине субстрата, а белый или зеленый налет — лишь вершина айсберга. К моменту появления визуальных признаков заражения колония уже разрослась по всему объему кейка, проникла в структуру и начала активное разрушение мицелия гриба.
Физическое удаление зараженного участка — будь то срез, соскоб или изоляция — не решает проблему, потому что остаются микроскопические гифы, невидимые невооруженным глазом. Они продолжают действовать, разрушая клетки Psilocybe даже без прямого контакта, за счет выделения ферментов и кислот, изменяющих pH и нарушающих обмен веществ.
Особенно критична стадия споруляции — когда триходерма приобретает характерный зеленый цвет. Это значит, что гриб завершил вегетативную фазу и начал массовое размножение. Одна спорулирующая зона может содержать миллионы микроспор, которые легко перемещаются по воздуху и оседают на всем — от фильтров и крышек до одежды и инструментов.
Именно поэтому частичная зачистка или «локальное лечение» не только бесполезны, но и опасны. Они увеличивают риск перекрестного заражения. Даже если удастся временно замедлить рост, споры уже находятся в помещении, и любая новая инокуляция будет происходить в загрязненной среде.
Что делать при обнаружении
Если вы заметили подозрительный участок на кейке или субстрате, важно действовать быстро, но аккуратно — от этого зависит судьба всей партии и санитарное состояние помещения:
- Не трогайте зараженный блок руками, скальпелем или перчатками. Даже легкое прикосновение может привести к распылению спор в воздухе.
- Плотно закройте блок в два слоя полиэтилена, стараясь не сжимать и не деформировать. Не открывайте банку или кейс — изолировать нужно именно в том виде, как он есть.
- Немедленно вынесите его из помещения, желательно в герметичном контейнере. Не проносите его через кухню, ванную или жилые зоны. Лучше использовать отдельный путь — балкон, лестницу, черновой выход.
- После удаления закройте доступ в помещение. Откройте окна и запустите сквозняк (если нет HEPA-фильтрации) — это снизит концентрацию спор в воздухе.
- Обработайте все поверхности 70% спиртом, 3% перекисью или раствором на основе гипохлорита натрия (но не смешивайте!). Особое внимание — столам, ручкам, крышкам, стенкам боксов.
- Если в помещении работал вентилятор или увлажнитель — остановите их.
- Разберите, промойте, обеззаразьте. В увлажнителе замените воду, при возможности — прокипятите его.
- На 48 часов отложите любые действия с культурами: инокуляции, перенесение блоков, проверку кейков. За это время проведите повторную уборку, протрите рабочие поверхности дважды.
- Если используется микропористый фильтрующий материал — либо замените его на новый, либо прокалите при температуре 180–200°C (если допустимо по материалу). Это касается и крышек с фильтрами.
Чего не стоит делать
При заражении триходермой интуитивно хочется «что-то предпринять», особенно если блок выглядит почти нормальным. Но большинство таких попыток приводят к ухудшению ситуации:
- не пытайтесь «дотянуть до урожая» — даже если появятся примордии, они будут слабыми, а споры плесени попадут на все помещение и оборудование;
- не срезайте пораженные участки — это не остановит заражение и только высвободит больше спор;
- не обрабатывайте зараженный блок перекисью, гипсом, солью или уксусом — поверхностные меры не проникают вглубь субстрата и создают ложное чувство контроля;
- не переселяйте кейк в другую камеру — вы лишь переместите контаминацию и заразите новое пространство;
- не открывайте банку или пакет с зараженным зерном на стадии инокуляции — проще и безопаснее герметично утилизировать его, не допуская распыления спор.
Главное — не жалеть субстрат. Один зараженный блок, оставленный в помещении, может обнулить усилия нескольких недель и испортить всю культуру.
Анализ источника заражения
После утилизации зараженного блока критически важно определить возможный путь попадания триходермы — без этого велика вероятность повторного заражения. Основные источники:
-
- недостаточная стерилизация субстрата — особенно актуально для плотно утрамбованных банок и перегретых автоклавов с холодными зонами;

- ошибки при инокуляции — открытие крышек вне ламинарного бокса, непродезинфицированные руки или инструменты, дыхание в зону работы без маски;
- нечистая культура или шприц — редко, но бывает при покупке у ненадежных поставщиков или неправильном хранении;
- загрязненный воздух — отсутствие фильтрации, старая вентиляция, сквозняки в момент инокуляции или пыльные поверхности;
- многоразовые фильтры и крышки — особенно если они хранились в открытом виде или не были повторно простерилизованы.
Разобравшись с причиной, имеет смысл:
- перенастроить цикл стерилизации (добавить контрольные пробные банки);
- пересмотреть зонирование (разделить зоны инокуляции и плодоношения);
- обновить расходники (заменить фильтры, шприцы, крышки);
- перепроверить культурный материал на стерильность.
Профилактика: короткий список без обобщений
- Стерилизация
Автоклав или скороварка — 121°C, не менее 90 минут. Плотные или влажные блоки требуют до 2 часов. При пастеризации — температура в центре 70°C, 90 минут. - Асептика при инокуляции
Работа рядом с пламенем, спиртовая лампа или ламинарный бокс. Перчатки, маска, обязательная обработка инструмента перед каждым использованием. - Изоляция стадий
Не совмещайте инокуляцию и плодоношение. Воздух из плодоносящей камеры не должен попадать в зону работы со стерильным материалом. - Контроль помещения
Не используйте жилые кухни, спальни и другие помещения с постоянной активностью. Лучше — отдельная зона с минимальным количеством вещей, текстиля и открытых поверхностей. - Проверка расходников
Фильтры, мешки, крышки — все должно храниться герметично. Повторное использование возможно только после полной обработки.
Почему триходерма — отдельный случай
Большинство плесневых грибов, с которыми сталкивается миколог, ведут себя как обычные конкуренты: они развиваются в тех же условиях, что и мицелий Psilocybe, и отнимают у него ресурсы. Но триходерма — не просто конкурент. Это активный микопаразит с целенаправленным разрушительным действием.
Ее поведение выходит за рамки пассивного потребления субстрата:
- она выделяет гидролитические ферменты, буквально растворяющие клеточные стенки другого гриба;
- снижает pH среды, создавая условия, неблагоприятные для роста мицелия;
- секретирует метаболиты, ингибирующие развитие плодового тела еще до контакта.
Добавьте к этому ее высокую летучесть (споры мгновенно поднимаются в воздух при любом движении), устойчивость к обеззараживанию, быструю колонизацию и умение выживать даже при пастеризации — и становится ясно, почему это не просто «контаминант», а системная угроза.
Даже при идеальной реакции на заражение высок риск, что споры уже осели на полках, инструментах или одежде. Поэтому к триходерме нельзя относиться как к обычной плесени. Это отдельная категория риска, требующая отдельного уровня подготовки и профилактики.
Заключение
Работа с мицелием — это система, в которой каждая деталь имеет значение. Заражение триходермой почти никогда не бывает «неожиданным» — чаще всего это результат нарушения одного из ключевых этапов: стерилизации, асептики или изоляции. Плесень не появляется из ниоткуда — она использует любую точку входа, и если система допускает такие прорехи, рано или поздно это произойдет.
Поэтому главный принцип грибоводства — не пытаться спасти зараженное, а оберегать чистое. Утилизация — не поражение, а профилактика. Очистка — не формальность, а залог следующего цикла. А повторное заражение — это не «невезение», а показатель того, что где-то осталась спора или забытый шаг.
Чистые циклы достигаются не благодаря хитростям, а благодаря стабильной, рутинной дисциплине: проверке температуры, герметичной упаковке, стерильным инструментам и чистому воздуху. В этом нет магии — только аккуратность и повторяемость. И именно это позволяет держать триходерму за пределами вашего гриба.
Источники:
- Fungi Academy. Mushroom contamination: How to spot and what to do.
- Grow Magik. Trichoderma in monotub mushroom growing.
- Alchimia Grow Shop. Contamination in magic mushroom cakes, what to do and how to prevent it?